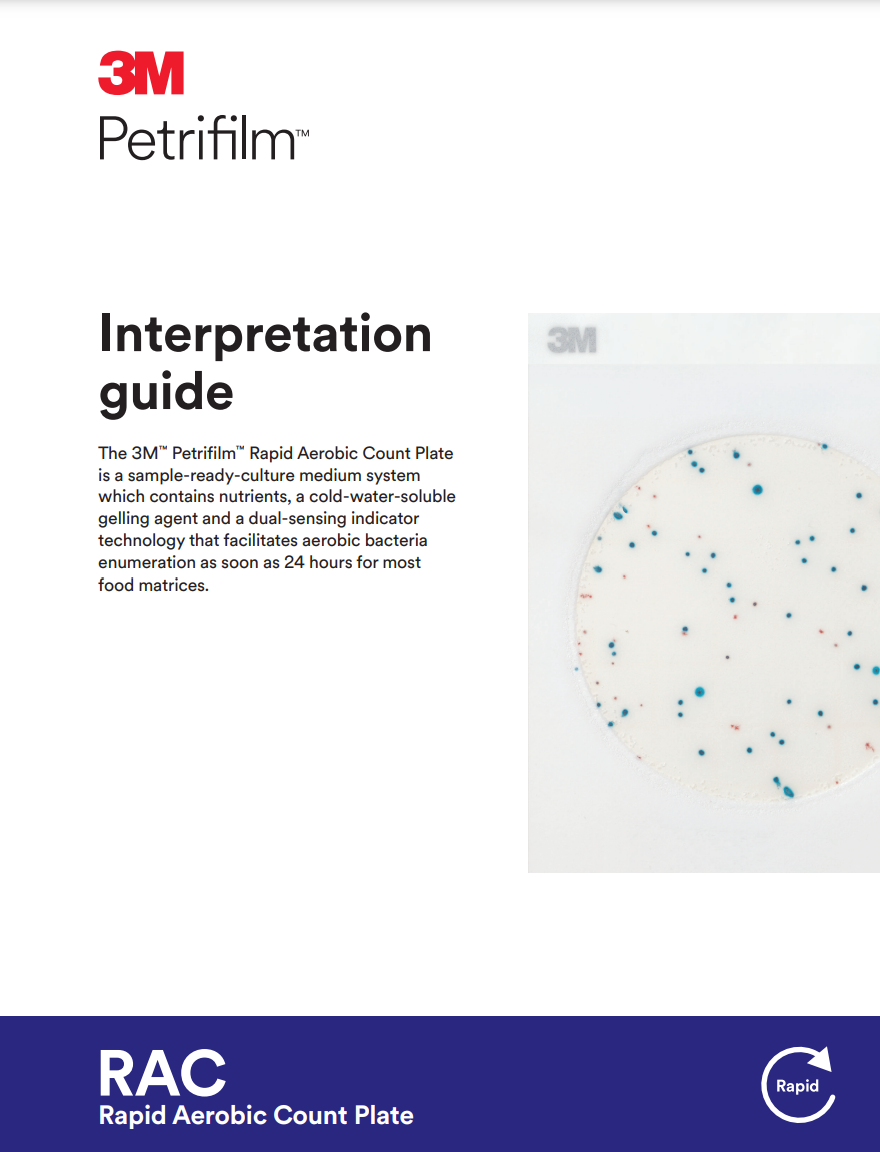

รหัสสินค้า 6478
฿ 5,500.00 (ยังไม่รวม Vat)
5,885.00 บาท
| จำนวน{{focus_pdata.unit}} |
ส่วนลดต่อ{{focus_pdata.unit}} |
ราคาสุทธิต่อ{{focus_pdata.unit}} |
| {{(typeof focus_pdata.price_list[idx+1] == 'undefined')?('≥ '+price_row.min_quantity):((price_row.min_quantity < (focus_pdata.price_list[idx+1].min_quantity - 1))?(price_row.min_quantity+' - '+(focus_pdata.price_list[idx+1].min_quantity - 1)):price_row.min_quantity)}} |
{{number_format(((focus_pdata.price_old === null)?focus_pdata.price:focus_pdata.price_old) - price_row.price,2)}}
บาท |
{{number_format(price_row.price,2)}} บาท |
Neogen™ Petrifilm™ Rapid Aerobic Count Plates(50 แผ่น/Pkg)
หมายเหตุ: รบกวนเช็คสต็อกก่อนการสั่งซื้อทุกครั้ง
สามารถสอบถามข้อมูลได้ที่ Line :@cwsci
หรือ อีเมล์ : sales.coolwool@gmail.com
| ข้อมูล |
น้ำหนัก
บาร์โค้ด
ลงสินค้า
อัพเดทล่าสุด
|
| รายละเอียดสินค้า |
3M™ Petrifilm™ Rapid Aerobic Count Plates(50 แผ่น/Pkg)
: Provides results as soon as 24 hours (excluding dairy powders) of incubation time
: Plates are sample-ready, eliminating the time-consuming, cumbersome step of preparing media/agar dishes
:Can be used with the 3M™ Petrifilm™ Plate Reader for consistent, fast, automated reading and recording of results. 
|
| เงื่อนไขอื่นๆ |
|
| Tags |
|
ขณะนี้ร้านค้าเปลี่ยนมาใช้ระบบรับชำระเงินผ่าน LnwPay กรุณาตรวจสอบข้อมูลวิธีการชำระเงินใหม่อีกครั้ง
รายละเอียดเพิ่มเติม
ช่องทางชำระเงิน

มาเป็นคนแรกที่รีวิวพรีเมี่ยมสินค้านี้ให้คนอื่นรับรู้ แถมรับคะแนนสะสม
LnwPoints ใช้เป็นส่วนลดในการสั่งซื้อครั้งต่อไป